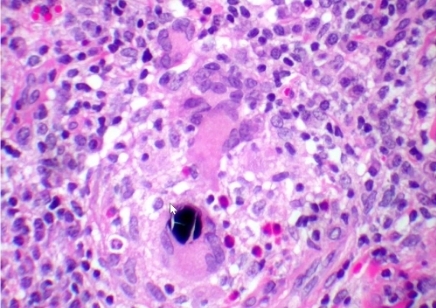

What is a perulis?
terminal end of a sinus tract
- leaks pus
What is the predominate cell type?

neutrophils
What is the predominate cell type in acute inflammation?
neutrophils
What is the predominate cell type in pus?

periapical radiolucency
- tooth also has a carious lesion
What does the histology look like for a periapical abscess?

- mostly neutrophils
What can a periapical radiolucency be?
- periapical abscess
- periapical granuloma
- periapical cyst
What does the histology look like for a periapical granuloma?
- connective tissue with many types of inflammatory cells
- macrophages
- plasma cells
- neutrophils
- lymphocyte
- DO NOT SEE EPITHELIUM

What does the histology look like for a periapical cyst?
- Epithelium!!
- macrophages
- plasma cells
- some neutrophils

What is the main difference between a periapical abcess, granuloma, and cyst?
abscess - mostly neutrophils
granuloma - NO epthelium and mix of inflammatory cells
cyst - epithelium and mix of inflammatory cells

- lymphocyte
- macrophage
- plasma cell
- macrophage
- neutrophil
What happens to a salivary gland if inflammation is present?
- ducts are enlarged
- acinar tissue is gone
How does this photo of salivary gland tissue change if inflammation is present?


What are examples of infectious granulomas?
fungi
certain bacteria
What are the different types of granulomatous inflammation?
- infectious granulomas
- immune granulomas
- foreign body granulomas
What happens in granulomatous inflammation?
- pattern of chronic inflammation
- aggregates of epitheliod macrophages
- multinucleated giant cells
- mononuclear leukocytes principally lymphocytes and plasma cells
- fibrosis variable
What is this and what are the big cells?

- sarcoidosis: non-caseating granuloma
- multinucleated giant cells
What is sarcoidosis?
a systemic disease that affects the salivary glands
What are examples of different types of foreign body granulomas?
- suture material
- dental restorative material
- vegetable material
What is this an example of?
foreign body gingivitis
What type of tissue is this?

granulation tissue
Granulation tissue and granulomatous tissue are the same or different?
Different!
What are different terms that use the work “granuloma” but are not granulomatous tissue?
- pyogenic granuloma
- dental granuloma
- peripheral giant cell granuloma
- central giant cell granuloma


